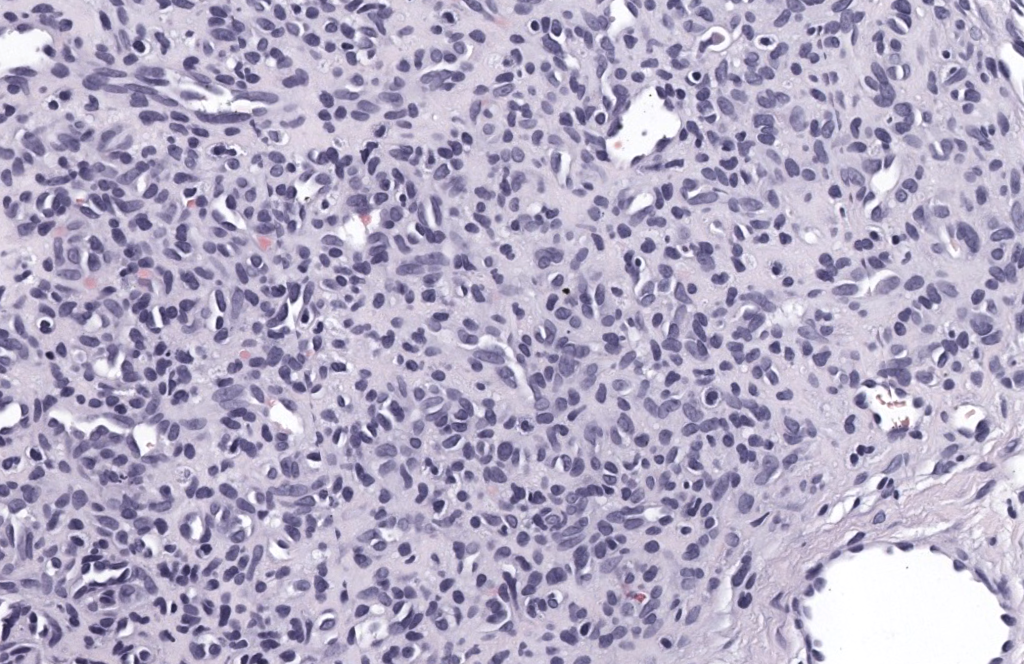

- Definición y sinónimos
- Tumor glómico (glomus tumor)
Neoplasia benigna perivascular originada en las células musculares lisas modificadas del cuerpo glómico neuromioarterial (cuerpo de Sucquet-Hoyer), estructura arteriovenosa especializada en la termorregulación digital. Se localiza típicamente en la dermis y tejido celular subcutáneo de los dedos, especialmente en la región subungueal. Samaniego 2009, Hazani 2008, Smith 2019 - Glomangioma / malformación glomovenosa (glomuvenous malformation, GVM)
Hoy se considera una malformación venosa congénita con proliferación de venas ectásicas cuyos vasos están rodeados por células tipo glómico, generalmente múltiple, congénita o de aparición precoz, hereditaria autosómica dominante por mutaciones de GLMN (glomulina). Boon 2004, Brouillard 2002 - En patología clásica de tumores glómicos se describen tres subtipos histológicos:
- Tumor glómico sólido
- Glomangioma (tumor glómico con componente vascular prominente)
- Glomangiomioma (con mayor componente de músculo liso) Samaniego 2009, Smith 2019
- Sinónimos frecuentes
- Tumor glómico subungueal
- Tumor glómico digital
- Glomangioma / malformación glomovenosa
- “Blue painful nodule” (glomangioma en dermatología vascular)
- Tumor glómico (glomus tumor)
- Historia
- Descrito clínicamente por Wood en 1812 y bautizado como “glomus tumor” por Masson en 1924. Samaniego 2009
- Epidemiología
- Tumor glómico clásico:
- Representa ~1–5 % de los tumores de la mano; de ellos, 25–75 % son subungueales. Samaniego 2009, Hazani 2008
- 75–80 % se localizan en extremidad superior, sobre todo región subungueal de dedos. Samaniego 2009
- Edad típica: adultos jóvenes y de mediana edad (20–50 años), pero descritos en todas las edades, incluidos niños. Hazani 2008, Singal 2022
- Ligero predominio femenino para las formas subungueales; extradigitales algo más frecuentes en varones. Samaniego 2009, Chou 2016
- Glomangioma / GVM:
- <10 % de las lesiones glómicas cutáneas. Samaniego 2009, Boon 2004
- Inicio típico en la infancia o adolescencia, con fuerte tendencia familiar (AD) y penetrancia variable. Brouillard 2002, Brouillard 2005, Brouillard 2013
- Tumor glómico clásico:
- Códigos CIE
- Tumor glómico cutáneo (benigno)
- ICD-10-CM
- D18.0 Hemangioma, cualquier sitio
- D18.01 Hemangioma de piel y TCS → código más lógico para tumor glómico cutáneo/subungueal
- ICD-11
- 2F2Y – “Other specified benign soft tissue tumour” (categoría donde se ubican glomus tumour benigno en la práctica dermatológica).
- ICD-10-CM
- Glomangioma / malformación glomovenosa (GVM)
- ICD-10
- Suele codificarse como D18.0 Hemangioma, cualquier sitio, o Q27.8 “Otras malformaciones congénitas del sistema vascular periférico” según enfoque local.
- ICD-11
- LC51 – “Developmental venous malformations involving the skin”, sinónimo oficial incluye glomuvenous malformation.
- ICD-10
- Checklist diagnóstico (rápido)
- Clínica mínima
- Dolor localizado intenso en dedo (especialmente subungueal)
- Sensibilidad al frío o exacerbación del dolor con bajas temperaturas
- Punto de máximo dolor bien circunscrito (+ Love test)
- ± Cambios ungueales (mácula rojiza/azulada, surco, hipercurvatura)
- Exploración complementaria recomendable
- Love test, signo de Hildreth, test de frío
- Onicoscopia / dermatoscopia ungueal
- Transiluminación (si disponible)
- Imagen (según caso)
- RM o ecografía:
- Si localización dudosa, lesión previa operada o recidiva
- Si se sospecha tumor profundo o extradigital
- RM o ecografía:
- Biopsia
- Tumor glómico típico subungueal: escisión completa (biopsia escisional) con inclusión de dermis y tejido celular subcutáneo
- GVM/lesiones múltiples: biopsia incisional en zona representativa
- Laboratorio/genética
- GVM o glomangiomas familiares: considerar estudio genético GLMN y asesoría genética
- Clínica mínima